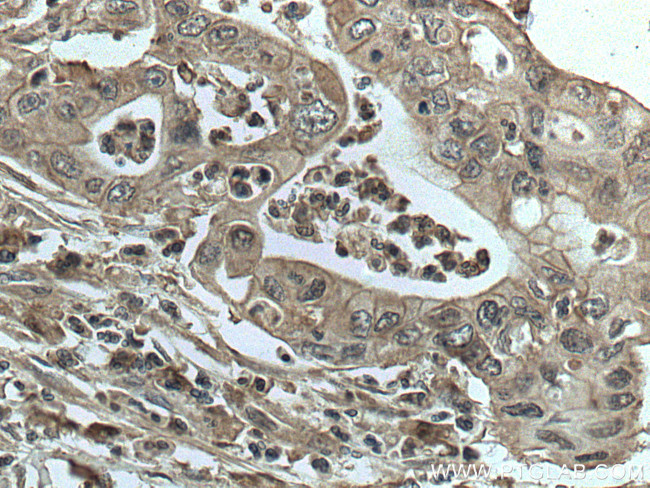
GRB2 Antibody in Immunohistochemistry (Paraffin) (IHC (P))

Search
Proteintech
GRB2 Monoclonal Antibody (1C5D11)
{{$productOrderCtrl.translations['antibody.pdp.commerceCard.promotion.promotions']}}
{{$productOrderCtrl.translations['antibody.pdp.commerceCard.promotion.viewpromo']}}
{{$productOrderCtrl.translations['antibody.pdp.commerceCard.promotion.promocode']}}: {{promo.promoCode}} {{promo.promoTitle}} {{promo.promoDescription}}. {{$productOrderCtrl.translations['antibody.pdp.commerceCard.promotion.learnmore']}}
产品信息
66880-1-IG
种属反应
宿主/亚型
分类
类型
克隆号
抗原
偶联物
形式
浓度
规格
纯化类型
保存液
内含物
保存条件
运输条件
产品详细信息
Aliquoting is unnecessary for -20°C storage.
靶标信息
GRB 2 protein contains one SH2 domain flanked on both sides by an SH3 domain. In response to EGF, GRB 2 binds, through its SH3 domains, to the guanine nucleotide exchange factor, Sos. The GRB 2-Sos complex then binds the EGF receptor. These interactions play a critical role in the activation of the p21 ras signaling pathway.
仅用于科研。不用于诊断过程。未经明确授权不得转售。
生物信息学
蛋白别名: abundant SRC homology; Adapter protein GRB2; adaptor protein; ASH protein; epidermal growth factor receptor-binding protein GRB2; epididymis secretory sperm binding protein; GRB2; Growth factor receptor-bound protein 2; growth factor receptor-bound protein 3; HT027; OTTHUMP00000166097; OTTHUMP00000166098; Protein Ash; SH2/SH3 adapter GRB2; unnamed protein product
基因别名: AA408164; ASH; EGFRBP-GRB2; GRB2; Grb3-3; MST084; MSTP084; NCKAP2
UniProt ID: (Human) P62993, (Mouse) Q60631, (Rat) P62994
Entrez Gene ID: (Human) 2885, (Mouse) 14784, (Rat) 81504